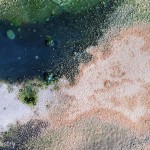

A note from Adil and more images of
“TRANSFORMATIONS – the sawchu barcode series.”
I embarked into unknown territories a month back….. painted the largest, my most ambitious episode yet…. the barcode panels are 2m in ht…..and stretch approx 8 to 10 meters in length.
Here are some images of the process and partly finished modules of “TRANSFORMATIONS – the sawchu barcode series.”
One needs to sit in and around them in quietude to feel their presence…………..come visit.
warmly,
Adil
assistance: Nicole
photography: Umeed Mistry
See earlier pictures here.